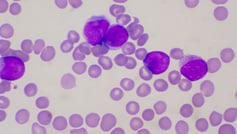
Search - UChicago Medicine

45 amazon gift card carding
Amazon Gift Cards | CrdPro - Carding forum Amazon Gift Cards. Thread starter ochoa; Start date Jul 31, 2022; O. ochoa Member. Joined 08.04.22 Messages 11 Reaction score 2 Points 3. Jul 31, 2022 ... Carding forum. CC-Street - BEST CC + CVV SHOP | FRESH WORLDWIDE and USA CC. Full Forum Access. HUEGOSTORE > BANKS, EXCHANGES, TLO, FULLZ, DOCS DRAWING ETC! Amazon_Gift_Card_Carding_Method_2016_WOR.txt - Course Hero Amazon Gift Card Carding Method 2016 ( WORK 100% ) - Easy Way 1, Put on UK VPN or SOCK5 2. Clear all cookies with ccleaner or any good software 3. Get UK cc (Visa works best) 3. Go to hotmail.com then create email with name of cc ( If cc name is John Smith, make [You must be registered and logged in to see this link.] or similar) 4. Go to amazon.co.uk and click gift card then select print now 5.
Amazon.com. Spend less. Smile more. Amazon.com. Spend less. Smile more.

Amazon gift card carding
Best Gift Card Carding Tricks and Cardable Sites 2020 This simply means that you are buying stuff for the owner. It will look real and Amazon will confirm your order almost immediately. Once confirmed, Your Gift Card Carding is almost complete. Now, visit Amazon e-giftcards and choose e-gift card amount below $500. Mail the gift card to your email address which is the outlook you created. amazon gift card carding method for free in 2022 Amazon gift card carding method steps Amazon giftcard carding method step 2: Amazon gift card carding method step 3 Amazon gift card carding method step 4 Amazon giftcard carding method step 5 Amazon giftcard carding method step 6 Amazon giftcard carding method step 7 Amazon giftcard received Gift card carding method Amazon Gift Card Carding Method (Full Guide For Beginner) Carding is easy but Amazon Gift Card carding is little hard, but worry not! We have come up with an amazing method and BIN by which you can easily card gift card on amazon. Amazon Gift Card. Flipkart Carding Method; We'll be fastening on how to card gift cards, specifically amazon gift cards.
Amazon gift card carding. Redeem a Gift Card - Amazon Customer Service Redeem a Gift Card When you redeem an Amazon.com Gift Card or gift voucher to your account, the funds are stored in Your Account and will automatically apply to your next eligible order. To redeem a gift card: Find the claim code. Go to Redeem a Gift Card. Enter your claim code and select Apply to Your Balance. Note: Amazon.com: gift card How do I purchase a gift card? To buy a gift card for someone, go to Gift Cards. Choose the type of gift card you want to purchase and the amount. Click Add to Cart, and then click Proceed to Checkout. Provide payment information for your purchase and click Continue. Click Place your order. CARDING - E-Gift Card CARDING Method | FSSQUAD E-GIFT CARD CARDING METHOD ( Steam wallet code, PlayStationNetwork (PSN) code, iTunes code, Google Play. Amazon giftcard, ...) Presenting here E-Gift card carding method of 2021 As I said this carding method is new and maybe you've never seen it before. But it 100% working and very simple. You need to buy CC before you can try this carding ... Amazon What can Amazon Gift Cards be redeemed towards? Gift Card is redeemable towards purchase of millions of eligible goods and services provided by Amazon.com Services LLC and its affiliates on , or certain of its affiliated properties, such as smile.amazon.com. Eligible goods and services are subject to change in our sole discretion.
Amazon.com Gift Card | Giftcards.com The Giftcards.com Visa ® Gift Card, Visa Virtual Gift Card, and Visa eGift Card are issued by Pathward, N.A., Member FDIC, pursuant to a license from Visa U.S.A. Inc. The Visa Gift Card can be used everywhere Visa debit cards are accepted in the US. No cash or ATM access. The Visa Virtual Gift Card can be redeemed at every internet, mail order, and telephone merchant everywhere Visa debit ... Free Amazon Gift Card Generator 2022 - Moneytells.com You can easily redeem gift card codes using the Amazon website. Here is the simple step-by-step procedure to redeem your amazon codes. Open Amazon website Now login into your amazon account. Go to the " Redeem Amazon Gift Card" Page. You're good to Paste or Type your generated Amazon gift code here. Amazon.com Gift Cards Print and fold an Amazon Gift Card at home. Get started Specialty gift cards Give a gift from their favorite brand. See all brands Amazon Reload Easily add funds to your gift card balance. Find out how Gift with Amazon Amazon.com eGift Card Amazon $5000 (873,230) Amazon.com eGift Card Amazon $5000 (873,230) Amazon.com eGift Card Amazon $5000 CARDING AMAZON GIFTCARD 2021.pdf - Course Hero CCAARRDDIINNGG AAMMAAZZOONN GGIIFFTTCCAARRDD 22002211 A LIST OF NECESSITIES FOR CARDING AMAZON GIFT CARDS 2021: 1. A new CC from a store or recognized seller (get a CC) 2. RDP (cardholder's state connection IP address) 3. Clean web history and cookies (use: Jet Cleaner / Ccleaner) 4. A valid and new email (don't use your current email, create one) 5. Amazon site Also read: A GUIDE TO ...
AMAZON LATEST GIFT-CARD TUT METHOD & NON VBV FULLZ ! EASY CARDING. - CrdPro Go to amazon and click gift card then select print now 5. Pick a design and amount as 10 Pounds (Trust me) 6. Put the name you are sending to with same last name as cc ( If cc name John Smith send to Jake Smith or similar) 7. Click add to order then carry on and create new account with email you ade ( john_smith@hotmail.co.uk) 8. whisper floss - kusne.evaboutique.shop Amazon giftcard carding method step 2: Amazon gift card carding method step 3. Amazon gift card carding method step 4. Amazon giftcard carding method step 5.yo pm me i got invites for 10 bucks a pop you can send me half up front and half after u register. hgn01 is the most legit card website i have came across lately and genesis.market is gold ... Amazon Gift Card Carding Method (Full Guide For Beginner) Carding is easy but Amazon Gift Card carding is little hard, but worry not! We have come up with an amazing method and BIN by which you can easily card gift card on amazon. Amazon Gift Card. Flipkart Carding Method; We'll be fastening on how to card gift cards, specifically amazon gift cards. amazon gift card carding method for free in 2022 Amazon gift card carding method steps Amazon giftcard carding method step 2: Amazon gift card carding method step 3 Amazon gift card carding method step 4 Amazon giftcard carding method step 5 Amazon giftcard carding method step 6 Amazon giftcard carding method step 7 Amazon giftcard received Gift card carding method

Losses from Carding: The Flaws of the Laws: A Comprehensive Review of Liability Frameworks for Unauthorized Uses of Credit Cards in the US, EU and ...
Best Gift Card Carding Tricks and Cardable Sites 2020 This simply means that you are buying stuff for the owner. It will look real and Amazon will confirm your order almost immediately. Once confirmed, Your Gift Card Carding is almost complete. Now, visit Amazon e-giftcards and choose e-gift card amount below $500. Mail the gift card to your email address which is the outlook you created.

:max_bytes(150000):strip_icc()/senior-woman-using-mobile-phone-while-holding-credit-card-619651112-e4ffaac2514f4236bf22abd722afeef2.jpg)




















:max_bytes(150000):strip_icc()/what-difference-between-prepaid-credit-card-and-gift-card_round2-fb12f0c05cc04888832041224c23a9a3.png)






0 Response to "45 amazon gift card carding"
Post a Comment